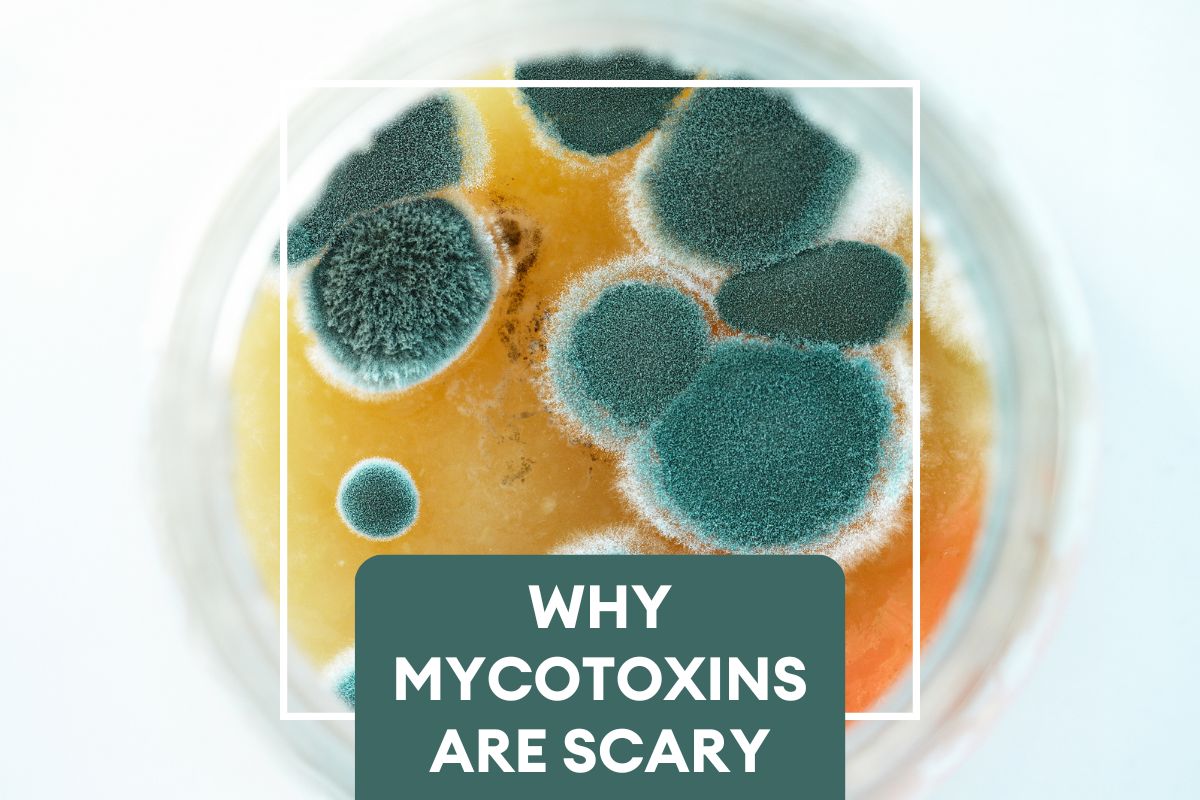

Articles, News and Press
mycotoxins
What are Mycotoxins? And why should you care?
Often the effects of coffee that we consider “bad” are not from the coffee bean itself, but rather mold growing on the coffee beans or inside your coffee brewer. Mold is a fungus, and is actually ...